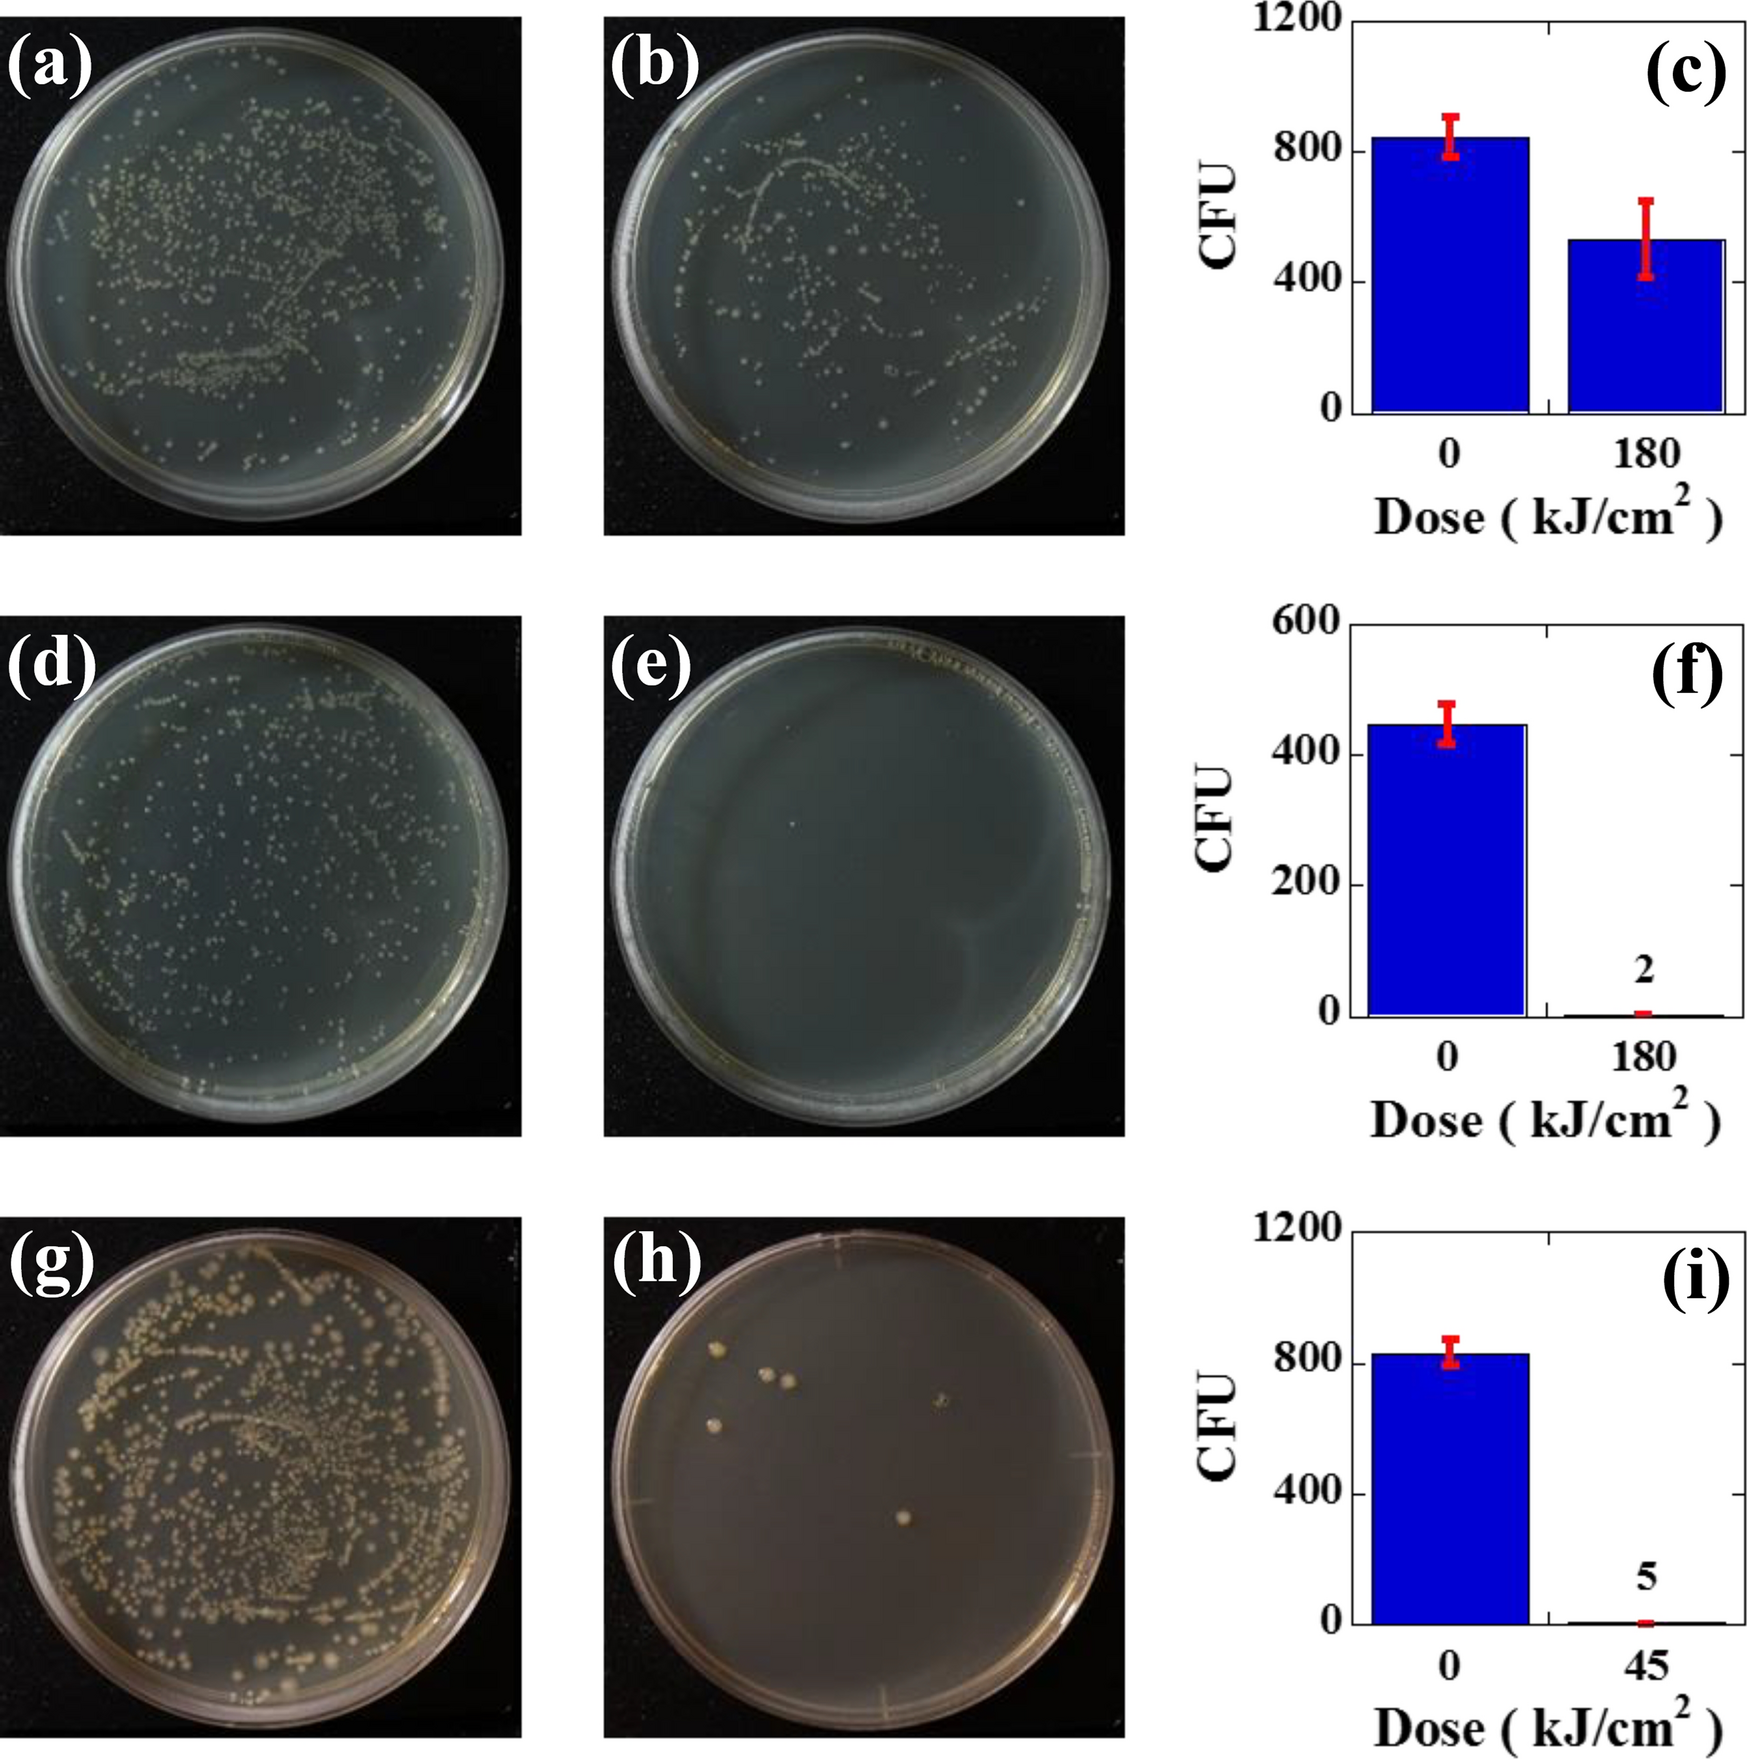
Figure 4

Figure 4
The results of the efficacy of inactivation for safranin-stained E. coli obtained by CW YAG laser irradiation: (a) control plate, (b) inactivated plate subjected to 180 kJ/cm2 irradiation, and (c) a bar graph showing the number of CFU for the control plate (845 ± 61 CFU) and inactivated plate (530 ± 116 CFU). The results of the efficacy of inactivation for safranin-stained E. coli obtained by pulsed YAG laser irradiation; (d) control plate, (e) inactivated plate subjected to 180 kJ/cm2 irradiation, and (f) a bar graph showing the number of CFU on the control plate (446 ± 30 CFU) and inactivated plate (2 ± 1 CFU). The results of the efficacy of inactivation for rhodamine B dye-stained E. coli obtained by pulsed YAG laser; (g) control plate, (h) inactivated plate subjected to 45 kJ/cm2 irradiation, and (i) a bar graph showing the number of CFU for the control plate (831 ± 39 CFU) and inactivated plate (5 ± 1.1 CFU).